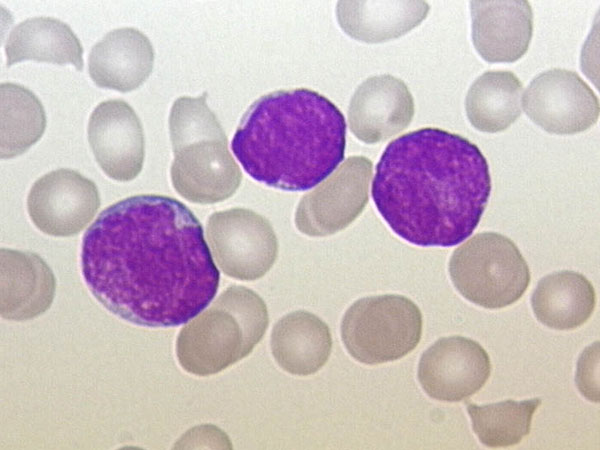
അര്‍ബുദം ഇതാണ്

Latest Updates
-
ഭക്ഷണത്തിന് ശേഷം ഏലക്കായ ചവക്കുന്ന ശീലമുണ്ടോ? നിങ്ങളറിയാതെ നിങ്ങള്ക്ക് ലഭിക്കുന്നത് ഇതെല്ലാം -
നേട്ടങ്ങളെത്തും കടല് പോലെ, മേടം മുതല് മീനം വരെ 12 രാശിക്കാര്ക്കും സമ്പൂര്ണ വാരഫലം: നിങ്ങള്ക്കെങ്ങനെ? -
Rashiphalam: ആഴ്ചാവസാനത്തില് മേടം മുതല് മീനം വരെ 12 രാശിക്കാര്ക്കും എപ്രകാരമാണ് ഫലങ്ങള് -
Rashiphalam: ഇന്ന് ഗജകേസരി രാജയോഗം, നേട്ടങ്ങളില് ഇവര് മുന്നില്: അറിയാം 12 രാശിക്കും സമ്പൂര്ണഫലം -
സമ്പൂര്ണ ന്യൂമറോളജിഫലം: അറിയാം നിങ്ങളുടെ ഭാഗ്യവും നിര്ഭാഗ്യവും ഈ ആഴ്ചയില് എപ്രകാരമെന്ന് -
ഡ്രാഗണ് ഫ്രൂട്ട് നിസ്സാരമല്ല: ഹൃദയം വരെ സുരക്ഷിതമാക്കും, ഗുണങ്ങളില് അതികേമന് -
ശനിയും ചൊവ്വയും ചേരുമ്പോള് ആഢംബരവും സമ്പത്തും ക്ഷണിക്കാതെ വന്നു ചേരും ഈ രാശിക്കാര്ക്ക് -
ഈദ് ആശംസകള് പ്രിയപ്പെട്ടവര്ക്ക്: പുണ്യമാസത്തിന്റെ ചെറിയ പെരുന്നാള് ആശംസകളറിയിക്കാം -
54 മണിക്കൂറോളം നീണ്ടുനില്ക്കും ഗജകേസരിയോഗം: മാര്ച്ച് 26 മുതല് 3 രാശിക്കാര്ക്കാണ് അനുഭവത്തില് മാറ്റങ്ങള് -
ബ്രൗണ്റൈസിനേക്കാള് കൂടുതലാണ് ഇവയില് ഫൈബര്: ദഹനത്തിനൊപ്പം ഊര്ജ്ജവും പ്രദാനം ചെയ്യും
ഋഷി കപൂറിന്റെ ജീവനെടുത്ത അര്ബുദം ഇതാണ്
ഇന്ന് അന്തരിച്ച പ്രമുഖ നടന് റിഷി കപൂര് (67) രക്താര്ബുദവുമായുള്ള നീണ്ട പോരാട്ടത്തിന് ശേഷമാണ് നമ്മളെ വിട്ട് പിരിഞ്ഞത്. രണ്ട് വര്ഷങ്ങള്ക്ക് മുമ്പ് 2018 ല് താരത്തിന് ഈ രോഗം കണ്ടെത്തിയിരുന്നു. ഏകദേശം ഒരു വര്ഷത്തോളം യുഎസില് അസ്ഥി മജ്ജ ചികിത്സയ്ക്ക് വിധേയനായിരുന്നു ഇദ്ദേഹം. എന്നാല് എന്താണ് ഈ രക്താര്ബുദത്തിന്റെ ലക്ഷണങ്ങള്. എന്തൊക്കെയാണ് ഇതിന് പരിഹാരം, എന്തുകൊണ്ടാണ് ഇത് ഗുരുതരമാവുന്നത് എന്നുള്ളതെല്ലാം അറിഞ്ഞിരിക്കേണ്ടതാണ്. കഴിഞ്ഞ ദിവസമാണ് നമ്മുടെ പ്രിയപ്പെട്ട താരം ഇര്ഫാന് ഖാന് വന്കുടലിലെ അര്ബുദം മൂലം മരണപ്പെട്ടത്.
ഇന്ന് ലോകത്തെ സിനിമാ പ്രേമികളെ സങ്കടത്തിലാക്കി ഋഷി കപൂറും വിട പറഞ്ഞിരിക്കുകയാണ്. എന്താണ് മൈലോയ്ഡ് ലുക്കീമിയ എന്ന് അറിഞ്ഞിരിക്കാം. ഇതില് മരണ സാധ്യതയും അതിന്റെ ഭീകരതയും എന്തൊക്കെയെന്ന് നമുക്ക് നോക്കാവുന്നതാണ്. മജ്ജ അസാധാരണമാം വിധം മൈലോബ്ലാസ്റ്റുകള് (ഒരുതരം വെളുത്ത രക്താണുക്കള്), ചുവന്ന രക്താണുക്കള് അല്ലെങ്കില് പ്ലേറ്റ്ലെറ്റുകള് എന്നിവയില് ഉണ്ടാക്കുന്ന ഒരു തരം കാന്സറാണ് മൈലോയ്ഡ് രക്താര്ബുദം എന്ന് പറയുന്നത്. ഇതിനെക്കുറിച്ച് കൂടുതല് അറിയുന്നതിന് വേണ്ടി വായിക്കൂ.

രക്താര്ബുദം എന്താണ്?
രക്തത്തിന്റെയും അസ്ഥിമജ്ജയുടെയും അര്ബുദമാണ് രക്താര്ബുദം. അസ്ഥിമജ്ജയില് സാധാരണയായി വികസിക്കുന്ന ഒരു കൂട്ടം ക്യാന്സറുകള്ക്ക് പറയുന്ന പൊതുവായ പേരാണ് ഇത്. നമ്മുടെ ശരീരത്തിന് ആരോഗ്യകരമായ രക്താണുക്കള് രൂപപ്പെടാന് കഴിയാത്ത അവസ്ഥയാണ് രക്താര്ബുദം. മിക്ക കേസുകളിലും, ശ്വേത രക്താണുക്കളില് (ഡബ്ല്യുബിസി) രക്താര്ബുദം വികസിക്കുന്നു, എന്നാല് ചില സന്ദര്ഭങ്ങളില് ഇത് ചുവന്ന രക്താണുക്കളിലും (ആര്ബിസി) അല്ലെങ്കില് പ്ലേറ്റ്ലെറ്റുകളിലും ഇവ രൂപം കൊള്ളുന്നുണ്ട്.

രക്താര്ബുദം എന്താണ്?
നമ്മുടെ ശരീരത്തില്, ആര്ബിസി, ഡബ്ല്യുബിസി, ബ്ലഡ് പ്ലേറ്റ്ലെറ്റുകള് എന്നിവയുടെ ഉത്പാദനത്തിന് അസ്ഥി മജ്ജ കാരണമാകുന്നു. അസ്ഥിമജ്ജ അതിന്റെ കോശങ്ങളിലെ ചില തകരാറുകള് കാരണം പക്വതയില്ലാത്ത കോശങ്ങള് ഉത്പാദിപ്പിക്കാന് തുടങ്ങുമ്പോഴാണ് രക്താര്ബുദം ഉണ്ടാകുന്നത്. കോശങ്ങളുടെ അസാധാരണത്വം രോഗങ്ങള്, അണുബാധകള്, മറ്റ് അസാധാരണതകള് എന്നിവയ്ക്കെതിരെ പോരാടുന്നതിന് അവരെ ഫലപ്രദമല്ലാതാക്കുന്നു. കൂടാതെ, അവ അതിവേഗത്തില് വിഭജിക്കുകയും സാധാരണ രക്താണുക്കളുടെ ഉത്പാദനത്തില് തടസ്സമുണ്ടാക്കുകയും ചെയ്യുന്നു.

റിഷി കപൂറിന്റെ രക്താര്ബുദം
അക്യൂട്ട് മൈലോയ്ഡ് രക്താര്ബുദം (എഎംഎല്) ബാധിച്ചയാളാണ് റിഷി കപൂര്. അസ്ഥിമജ്ജയിലെ മൈലോയ്ഡ് കോശങ്ങളില് വികസിക്കുന്ന രക്താര്ബുദത്തിന്റെ ഒരു തരമാണിത്. ആര്ബിസി, പ്ലേറ്റ്ലെറ്റുകള്, ലിംഫോസൈറ്റുകള് ഒഴികെയുള്ള എല്ലാ ഡബ്ല്യുബിസിയുടെയും മൈലോയ്ഡ് അല്ലെങ്കില് മൈലോജെനസ് സെല്ലുകള് ഉള്പ്പെടുന്നു. ഇവ പലപ്പോഴും ശരീരത്തിന്റെ രോഗപ്രതിരോധ ശേഷിയെ തന്നെ നശിപ്പിക്കുന്ന അവസ്ഥയിലേക്ക് കാര്യങ്ങളെ എത്തിക്കുന്നുണ്ട്. 60 വയസ്സിനു മുകളിലുള്ള മുതിര്ന്നവരില് ഇത്തരത്തിലുള്ള ലുക്കീമിയ ബാധിക്കുന്നതിനുള്ള സാഹചര്യം വളരെ കൂടുതലാണ്. എന്നിരുന്നാലും, ഏത് പ്രായത്തിലും ഇത് സംഭവിക്കാം. സ്ത്രീകളേക്കാള് പുരുഷന്മാരിലും ഈ രോഗം വരാനുള്ള സാധ്യത കൂടുതലാണ്.

രക്താര്ബുദത്തിന്റെ ലക്ഷണങ്ങള്
നിരന്തരമായ ക്ഷീണം, ശ്വാസം മുട്ടല്, തലകറക്കം, അമിത രക്തസ്രാവം, അസ്ഥി വേദന, വീര്ത്ത മോണകള്, വീര്ത്ത കരള്, നെഞ്ച് വേദന എന്നിവയാണ് രക്താര്ബുദത്തിന്റെ ലക്ഷണങ്ങളില് പ്രധാനപ്പെട്ടത്. അതുകൊണ്ട് തന്നെ ഇത്തരം കാര്യങ്ങള് വളരെയധികം ശ്രദ്ധിക്കേണ്ടതാണ്. അതുകൊണ്ട് തന്നെ ഇത്തരം കാര്യങ്ങള് ശ്രദ്ധിച്ചാല് അത് നിങ്ങളുടെ ആരോഗ്യത്തെ വളരെയധികം സഹായിക്കുന്നുണ്ട്. നേരത്തെ കണ്ടെത്തിയാല് പൂര്ണമായും ചികിത്സിച്ച് ഭേദമാക്കാന് സാധിക്കുന്നതാണ് ഏത് അര്ബുദവും.

രക്താര്ബുദത്തിന്റെ കാരണങ്ങള്
റേഡിയേഷന് വളരെയധികം കൂടുതലാവുന്ന അവസ്ഥ. കൂടുതല് കാലം ബെന്സീന് പോലുള്ള രാസവസ്തുക്കളുമായി ഉയര്ന്ന എക്സ്പോഷര്, മറ്റ് ക്യാന്സറുകള്ക്കുള്ള കീമോതെറാപ്പി ചെയ്യുന്നവര്, ഡൗണ് സിന്ഡ്രോം പോലുള്ള ചില അവസ്ഥകള്, ചില അവസ്ഥകളില് പാരമ്പര്യം (അപൂര്വ സന്ദര്ഭങ്ങളില്) മുമ്പുണ്ടായിരുന്ന രക്ത വൈകല്യങ്ങളായ മൈലോഫിബ്രോസിസ്, അപ്ലാസ്റ്റിക് അനീമിയ, പുകവലി എന്നിവയെല്ലാം പലപ്പോഴും രക്താര്ബുദത്തിന്റെ കാരണങ്ങളില് പെടുന്നുണ്ട്. അതുകൊണ്ട് തന്നെ വളരെയധികം ശ്രദ്ധിക്കേണ്ടതുണ്ട്.

അക്യൂട്ട് മൈലോയ്ഡ് രക്താര്ബുദ ചികിത്സ
ഇത്തരത്തിലുള്ള അര്ബുദത്തിന്റെ ചികിത്സ രോഗത്തിന്റെ തീവ്രത, പ്രായം, മൊത്തത്തിലുള്ള ആരോഗ്യം, എന്നിങ്ങനെയുള്ള നിരവധി ഘടകങ്ങളെ ആശ്രയിച്ചിരിക്കുന്നു. ഇവക്കെതിരേയുള്ള ചികിത്സാ രീതികള് വളരെയധികം ഫലപ്രദമാണ്. ഏതൊക്കെ ചികിത്സാ രീതികളാണ് ഇത്തരത്തില് നിങ്ങളില് രോഗമുക്തിക്ക് സഹായിക്കുന്നത് എന്ന് നോക്കാം. രോഗിയുടെ പ്രായവും രോഗത്തിന്റെ ഘട്ടം എന്നിവ കൃത്യമായി മനസ്സിലാക്കിയ ശേഷം മാത്രമേ ചികിത്സ ആരംഭിക്കുകയുള്ളൂ.
അര്ബുദം ഇതാണ്
റിമിഷന് ഇന്ഡക്ഷന് തെറാപ്പി: രക്തത്തിലെയും അസ്ഥിമജ്ജയിലെയും രക്താര്ബുദ കോശങ്ങളെ ലക്ഷ്യം വച്ച് ഇല്ലാതാക്കുന്ന ചികിത്സയുടെ ആദ്യ ഘട്ടമാണിത്.
ഏകീകൃത തെറാപ്പി: മുകളില് പറഞ്ഞ നടപടിക്രമങ്ങള് പാലിക്കുന്നു, അവശേഷിക്കുന്ന രക്താര്ബുദ കോശങ്ങള് ഉണ്ടെങ്കില് അവ നശിപ്പിക്കപ്പെടുന്നു.
കീമോതെറാപ്പി: ഈ പ്രക്രിയയില്, കാന്സര് കോശങ്ങളെ കൊല്ലാന് രാസവസ്തുക്കള് ഉപയോഗിക്കുന്നു.
മജ്ജ മാറ്റിവയ്ക്കല്: സ്റ്റെം സെല് ട്രാന്സ്പ്ലാന്റ് എന്നും വിളിക്കപ്പെടുന്ന ഈ ചികിത്സാരീതി അനാരോഗ്യകരമായ അസ്ഥി മജ്ജയെ ആരോഗ്യകരമായ ഒന്ന് ഉപയോഗിച്ച് ആരോഗ്യകരമായ രക്താണുക്കളുടെ ഉത്പാദനം പുനരുജ്ജീവിപ്പിക്കുന്നു



Click it and Unblock the Notifications
